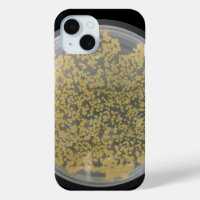
Plaque de culture de bactéries recouverte de colon

Cartes de visite juridique et finance
Cartes de visite marketing et com
Cartes de visite sport et fitness
Cartes de visite beauté et soins
Cartes de visite BTP et artisanat
Cartes de visite restauration
Cartes de visite photographie
Cartes de visite santé et bien-être
Colonne Coques & Protections pour iPhones
Colonne Coques & Protections pour iPhones
152 résultats
Produits
< Électroniques & Accessoires High-Tech
< Coques & Accessoires Pour Téléphones
Coques Pour iPhone 8 Plus/7 Plus
Coques Pour iPhone 8/7
Coques Pour iPhone 11
Coques Pour iPhone 11 Pro
Coques Pour iPhone 11 Pro Max
Coques Pour iPhone 12
Coques Pour iPhone 12 Pro Max
Coques Pour iPhone 15
Coques Pour iPhone 15 Pro Max
Coques iPhone 16
Coques iPhone 16 Pro Cases
Coques iPhone 17
Coques Pour iPhone X
Coques Pour iPhone 14
Coques Pour iPhone 14 Plus
Coques Pour iPhone 14 Pro
Coques Pour iPhone 14 Pro Max
Coques iPhone 16 Plus
Coques iPhone 16 Pro Max
Coques Pour iPhone 5/5S
Coques Pour iPhone Xr
Coques Pour iPhone Xs
Coques Pour iPhone Xs Max
Coques Pour iPhone 13
Coques Pour iPhone 13 Mini
Coques Pour iPhone 13 Pro
Coques Pour iPhone 13 Pro Max
Case-Mate iPhone Case Printemps Botticelli
Prix58,15 $CA
Coque iPhone 16 Pro Daniel Boone escortant des colons
Prix42,00 $CA
Coque Pour iPhone 14 Colonnes KCFX
Prix56,85 $CA
Coque Pour iPhone 14 Plus Fan côlon vivant
Prix60,15 $CA
Etui iPhone Case-Mate Antarctique, Territoire antarctique australien, 7
Prix68,80 $CA
Produit sous licence officielle
Coque iPhone 11 Carte : L'Amérique du Nord, C1700
Prix65,00 $CA
Case-Mate iPhone Case Colonie de fourmi
Prix68,75 $CA
La musique est dans ma colonne coque
Prix56,85 $CA
Coques Pour iPhone Vue de la colonne de Constantine et du Principa
Prix65,00 $CA
Produit sous licence officielle
Case-Mate iPhone Case Drapeau américain 1776
Prix56,85 $CA
Coque Case-Mate Pour iPhone Fleurs et colonnes, Fort de Jaisalmer, Jaisalmer,
Prix68,80 $CA
Produit sous licence officielle
Coques Pour iPhone Grèce et île grecque de Santorin ville d'Oia 2
Prix68,80 $CA
Produit sous licence officielle
Coque iPhone 11 Monsieur Francis Drake
Prix65,00 $CA
Lignes irrégulières - Blanc sur coque iphone noir
Prix73,10 $CA
Coque-portefeuille iPhone 5 Incipio Watson™ Arrière - plan de mosaïque
Prix94,65 $CA
Produit sous licence officielle
La Promesse Zazzle
Garantie Coup de Coeur
Vous ne l'aimez pas ? Nous le reprenons ! 30 jours pour choisir, notre "Garantie 100% coup de cœur".
Livraison Internationale Simplifiée
Expédition sans soucis, sans frais cachés. Nous couvrons les frais de douane.
Achats Sécurisés Garantis
Paiement 100% sécurisé grâce au cryptage SSL.
Avis sur la recherche
Si vous avez besoin d'assistance ou si vous avez une question, consultez notre Aide